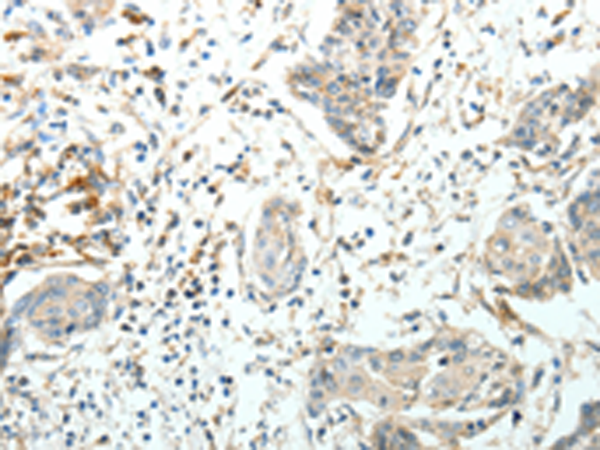

中文名稱: 兔抗FZD3多克隆抗體
|
Background: |
This gene is a member of the frizzled gene family. Members of this family encode seven-transmembrane domain proteins that are receptors for the wingless type MMTV integration site family of signaling proteins. Most frizzled receptors are coupled to the beta-catenin canonical signaling pathway. The function of this protein is unknown, although it may play a role in mammalian hair follicle development. Alternative splicing results in multiple transcript variants. This gene is a susceptibility locus for schizophrenia. |
|
Applications: |
ELISA, IHC |
|
Name of antibody: |
FZD3 |
|
Immunogen: |
Synthetic peptide of human FZD3 |
|
Full name: |
frizzled family receptor 3 |
|
Synonyms: |
Fz-3 |
|
SwissProt: |
Q9NPG1 |
|
ELISA Recommended dilution: |
1000-2000 |
|
IHC positive control: |
Human cervical cancer |
|
IHC Recommend dilution: |
15-50 |
購物車
幫助
021-54845833/15800441009
